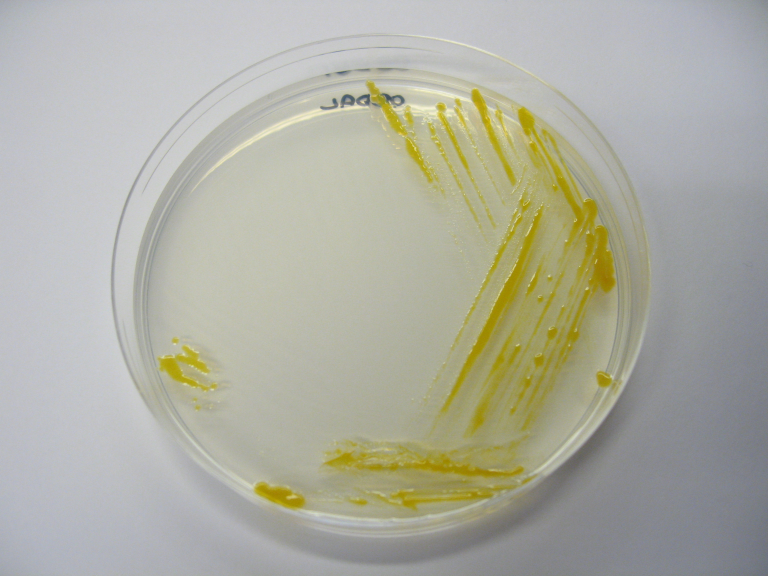
20250117 Faktaside Flavo_foto_Hanne Nilsen.png

Flavobacterium psychrophilum
Bakterien Flavobacterium psychrophilum er årsaken til sykdom hos laksefisk i fersk- og brakkvann, og regnbueørret (Oncorhynchus mykiss) er regnet for å være en særlig mottakelig art.
Systemisk infeksjon med F. psychrophilum hos regnbueørret er listeført i Norge (kategori F), og forekomst av, eller mistanke om sykdommen, skal straks rapporteres til Mattilsynet.
Smittestoff og smitteveier
Flavobacterium psychrophilum hører til i bakterieslekten Flavobacterium som inneholder gulpigmenterte, lange og glidende stavbakterier. Bakterien trenger spesielle vekstmedium og vokser sent i laboratoriet (3-6 dager). Bakterien kan deles inn i flere biotyper, serotyper og genotyper (også kalt sekvenstyper), basert på ulike egenskaper og arvemateriale (DNA).
Evne til å framkalle sykdom varierer mellom ulike stammer av bakterien og hvor mottagelig verten er. Ved sykdomsutbrudd hos laks og brunørret er det stor variasjon hos bakteriestammene som blir assosiert med syk fisk.
Ved utbrudd blir bakterien overført horisontalt fra fisk til fisk. Under norske forhold går en ut fra at bakterien også kan smitte mellom fisk i sjøvann i øvre vannlag med lav salinitet.
Vertikal overføring fra foreldre til avkom kan ikke utelukkes siden bakterien er funnet i både hunn- og hannlige kjønnsprodukt, og forsøk har vist at kolonisering av øyerogn med bakterien har gitt sykdom hos yngelen. I tillegg er det i flere land og geografiske områder vist at en og samme gruppe av stammer av F. psychrophilum som er i nær slekt, er knyttet til sykdomsutbrudd hos regnbueørret. Det epidemiologiske bildet ved utbrudd av sykdommen støtter også dette.
Bakterien har evne til å danne biofilm, noe som gjør at den kan overleve lenge i miljøet.
Sykdomstegn
Sykdommen som bakterien forårsaker, kalles Bacterial Cold Water Disease (BCWD) og Rainbow Trout Fry Syndrome (RTFS).
Hos regnbueørretyngel kan en se dårlig matlyst, spiralsvømming og svømming i overflaten. Det er ikke uvanlig med en kort krampefase før døden. Fisken har stor buk, og syk fisk kan i starten virke mørk, for så senere å bli lysere pga. anemi og/eller ødemtendens. En kan av og til se milten gjennom bukveggen som en rød flekk. «Helikopterhaler» er registrert i populasjoner som har gjennomgått kliniske utbrudd av RTFS i Norge.
Hos større fisk er det vanligere med hudlesjoner som blodige «byller», åpne sår og finneråte. Væske i buk og anemi er vanlige observasjoner.
Diagnostikk
Ved Veterinærinstituttet blir sykdomsdiagnosen stilt ved hjelp av sykehistorie, patologiske og mikrobiologiske undersøkelser. Diagnosen blir bekreftet ved dyrking og identifisering av bakterien.
Funn av typiske mikroskopiske vevsforandringer (histopatologi), påvising av bakterielle antigener i vev ved hjelp av immunologisk metodikk (immunhistokjemi) og/eller positive PCR-analyser utløser mistanke og støtter diagnosen.
Ved gransking av vevsbiter i lysmikroskop er typiske funn nekrose og blodstuvning i milten. Miltkapselen kan være erstattet av eosinofilt materiale og/eller granulasjonsvev. Fisken kan ha hjertesekk- og hjertemuskelbetennelse med varierende forekomst av polymorfkjernede leukocytter. Lange, slanke bakterier kan ofte påvises i forbindelse med patologiske forandringer.
F. psychrophilum er en strikt aerob, gul, gramnegativ, lang, trådformet bakterie som vokser på spesialmedium. Vanlig brukte medium er Anacker og Ordal, KDM og TYES. Identifikasjon av bakterien baserer seg på fenotypiske karakteristika og identifisering ved hjelp av massespektrometri (MALDI_TOF_MS) og/eller sekvensering av DNA (arvemateriale). En kvantitativ molekylærbiologisk metode (rtPCR) er etablert ved Veterinærinstituttet.
Det er vanlig å genotype F. psychrophilum ved Veterinærinstituttet ved hjelp av MLST (multilocus seksvenstyping).
Forekomst
F. psychrophilum er først og fremst årsaken til sykdom hos laksefisk i ferskvann, men er også påvist hos andre arter. Av laksefisk er regnbueørret (Oncorhynchus mykiss) og sølvlaks (Oncorhynchus kisutch) regnet for å være spesielt mottakelige arter. I tillegg er sykdom hos ayu (Plecoglossus altivelis) identifisert som et problem i japansk oppdrett.
I Norge har sykdomsproblem assosiert med denne bakterien variert fra år til år. I 2008 oppstod en avgrenset, men alvorlig epidemi med høy dødsrate hos regnbueørret i flere settefiskanlegg. I de senere årene har det vært få påvisinger hos regnbueørret i settefiskfasen. Derimot ser det ut til at sykdommen har etablert seg hos regnbueørret etter sjøsetting i et fjordsystem på Vestlandet.
Bakterien blir regelmessig isolert fra ørret (Salmo trutta) og laks (Salmo salar) i kultiveringsanlegg og kommersielle settefiskanlegg i forbindelse med sår og finneråte. Systemisk infeksjon (infeksjon i indre organer) er blitt påvist også hos laks på enkelte settefisklokaliteter om vinteren.
F. psychrophilum ble første gang isolert fra syk sølvlaks i USA i 1960, mens sykdommen allerede ble beskrevet i 1946. Infeksjonen dukket opp på det europeiske kontinentet hos regnbueørret i midten av 1980-åra, og er i dag sett på som et av de største problemene i verden for produksjon av regnbueørret.
Tiltak
Systemisk infeksjon med F. psychrophilum hos regnbueørret er listeført i Norge (kategori F).
Vaksinering av yngel har til nå ikke gitt tilfredsstillende resultat. Det er rapportert at både mono- og multivalente injeksjonsvaksiner gir beskyttelse hos større fisk. En kombinasjonsvaksine som inneholder Flavobacterium psychrophilum er tilgjengelig på det norske markedet.
Suboptimale miljøforhold og stress kan trolig utløse sykdommen.
Sykdommen kan kontrolleres med hygieniske tiltak, og det kan være nødvendig med medikamentell behandling. Internasjonalt er utvikling av resistens mot vanlig brukte antibakterielle midler et økende problem. F. psychrophilum-stammer funnet hos regnbueørret i Norge har hatt nedsatt følsomhet for enkelte antibakterielle midler (kinoloner). Tilbakefall i fiskegrupper som har vært behandlet er ikke uvanlig.
Bakterien er følsom for vanlig brukte desinfeksjonsmidler, og for å unngå overføring av bakterien fra foreldrefisk til avkom via kjønnsprodukt, er det svært viktig med streng hygiene og optimale desinfeksjonsrutiner. Desinfeksjon av rogn er påbudt, og jodoforer er vanlig å bruke.
